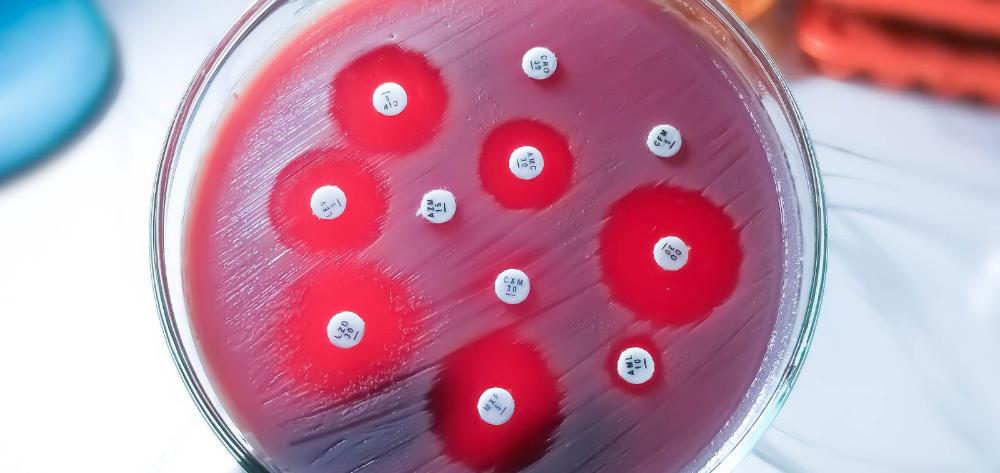

SWe will keep you updated on our activities and scientific studies.
Cookies and privacy
You will not find any advertising or personalised tracking cookies on this website. We only use our own and third party cookies to improve your browsing experience, to protect your privacy, to know how many people visit us and what content is of most interest, such as Google's analytics cookies. You can "Accept All Cookies", "Reject Optional Cookies" (except necessary technical cookies) and "Configure Cookies". Please refer to our Cookie Policy and Privacy Policy for more details.
Cookies Policy

Our website www.isglobal.org (the "Website") uses cookies to collect information on how the Website is used.
A cookie is a file downloaded onto your machine (computer or mobile device) for storing data that may be updated and retrieved by the entity that installed it.
The information collected via cookies may include the date and time you visited the website, the pages you viewed, the time you spent on our website and the websites you visited before and after visiting our site.
We use cookies to facilitate your browsing of our Website, distinguish you from other users, provide you a better use experience and identify problems with our Website. If you provide your consent, we will use cookies to obtain information on your preferences and tailor our Website to your interests.
The purpose of this cookies policy is to provide you with clear and precise information on the cookies used on our Website (the "Cookies Policy"). For more information on the cookies used on our Website, please email your questions to the Data Protection Officer: lopd@isglobal.org.
Type of cookies used on the Website
Our Website uses the cookies described below.
First-party cookies
These cookies are sent to your computer and handled only by us to improve the operation of the Website. Information collected is used to improve the quality of our service and your user experience. These cookies remain in your browser for longer. This allows us to recognise you when you return to the Website and tailor the content offered to your preferences.
Third-party analytics cookies
Interacting with the content of our Website can also cause the installation of third-party cookies (e.g., when you click on social network buttons or watch videos hosted on our Website). Third-party cookies are installed by other domains; not ours. We cannot access the data stored in the cookies of other websites when you browse those websites.
Our Website uses Google Analytics audience measurement system, Facebook, First Party, Twitter, Vimeo, YouTube, Instagram, Issuu and Opinion Stage. These tools allow us to know how users interact with our Website. We use "persistent" cookies. Persistent cookies store data on your terminal that can be accessed and processed during a defined time period by the owner of the cookie. This time period could be anything from a few minutes to several years.
Below is a list of cookies according to the purpose for which the data obtained is processed:
- Technical cookies. These cookies allow you to browse a webpage, platform or application and use the options of the services you find there. For instance, they are used for monitoring web traffic and data communication, identifying the session, providing access to restricted areas, remembering elements in an order, carrying out the purchasing process of an order, performing a request for enrolment or participation in an event, using security elements during browsing, storing content for the playing of audiovisuals, and sharing content via social networks.
- Personalisation cookies. These allow you to access the service and have some general characteristics predefined based on a series of criteria found in your terminal, such as language, browser type with which you are accessing the service, regional configuration from where you are accessing the service, etc.
- Analytics cookies. These cookies allow monitoring and analysing user behaviour on a website. Information collected via this type of cookie is used to measure the activity of websites, applications or platforms and for creating the browsing profiles of users of these sites, applications and platforms. This allows introducing improvements based on the analysis of user usage of the service.
- Advertising cookies. These allow managing, in the most effective manner possible, advertising spaces.
- Behavioural advertising cookies. These cookies store information on user behaviour obtained via the continual monitoring of their browsing habits, which allows creating a specific profile for displaying targeted advertising based on this information.
- External social network cookies. These cookies are used so visitors to websites can interact with the content of social networks (Facebook, YouTube, Twitter, LinkedIn, etc.). They are generated only for the users of these social networks. The conditions of use of these cookies and the information collected is governed by the privacy policy of the social network platform in question.
Along with our server's log files, these cookies tell us the total number of visitors to our Website and which parts of our site are the most popular. Thanks to them, we obtain information that helps us improve browsing and provide a better service to our users and clients.
Visit the following link to Google's website to read about the type of cookies used by Google Analytics and their expiry time.
Consent
By browsing and remaining on our Website, you provide consent for our use of the cookies described for the time periods specified under the conditions of this Cookies Policy.
Disabling and blocking cookies
Cookies are not required for using our Website. You can block and disable cookies by configuring your browser to block the installation of all or some cookies. Most browsers can be set to warn you of the presence of cookies or block them automatically. If you block cookies, you may continue using our Website. However, the use of some of its services may be limited, and your user experience may be diminished.
Withdrawing your consent
If at any time you want to withdraw the consent you gave under this Cookies Policy, delete the cookies stored on your machine (computer or mobile device) via the settings and configuration of your web browser.
For more information on deleting, disabling or blocking cookies, visit this page.
Changing your browser's cookie configuration and settings
Unless you have adjusted your browser's configuration, our system creates cookies when you visit our Website. All web browsers allow changing this configuration.
Click on the links below for how to adjust the cookie configuration of the following browsers:
Internet Explorer:
Firefox
Chrome
Safari (and for iOS)
Changes to the Cookies Policy
We may update the Cookies Policy of our Website from time to time. We recommend that you review this policy each time you visit our Website so that you are adequately informed on how and for what we use cookies. The Cookies Policy was last updated on March 11, 2020.
Contact
For any query, comment or suggestion regarding our Cookies Policy, please email the Data Protection Officer: lopd@isglobal.org.
[Updated on March 11, 2020 · Photo: Christopher Burns / Unsplash]
Privacy Policy

In accordance with the current data protection regulations, ISGlobal informs you of the following:
When you are requested to provide personal data for the provision of services, you will be informed of what data you must provide.
If you do not provide this required data, we will not be able to provide you with the services. The personal data you provide or that ISGlobal obtains as a result of your browsing, queries or requests via our webpage at www.isglobal.org (the “website”) will be included in a file owned by ISGlobal for managing, storing and tracking your requests for information and/or contracting of goods or services offered via the website. The information obtained from you by ISGlobal from the website when you sign up for a promotional event or send a form is processed with the utmost confidentiality for helping you to take part in the event in question or, in the second case, sending you the information you requested. The information obtained is not used for any other purpose. The personal data provided will not be disclosed or transferred to third parties without your consent.
When the completion of a form is requested, the user will be informed of the identity and data of the data controller and the Data Protection Officer, the purposes and legal basis of the treatment, the recipients of the data as well as, where appropriate, the international data transfers, the data retention periods and the user's ability to exercise their rights of access, rectification, deletion, portability, limitation and / or opposition to treatment, the right complaint to the control authority and the existence of automated decisions. The personal data collected will only be processed and / or transferred for the express purpose, and always with the consent of the user.
Information is only sent via the form(s) of the website after you have expressed your acceptance by selecting an "ACCEPT/SEND" (or similar) button, via which ISGlobal has proof that you gave your consent for it to process your personal data.
In all cases, you guarantee that the data you provide is true, exact, complete and up-to-date. ISGlobal may decline to provide the information or services requested to any user providing false data without prejudice to any other legal action open to it.
In virtue of Article 22 of Spanish Law 34/2002, of July 11, on the Information Society Services and Electronic Commerce, ISGlobal may store and retrieve "cookies" (data in a text file) from your machine, provided you have given consent and after we have provided you with clear and complete information on the use of these cookies. You may obtain complete information on the purpose for installing these cookies and what they are used for in ISGlobal's Cookies Policy.
This does not prevent any technical storage or access for the sole purpose of carrying out or facilitating the transmission of a communication over an electronic communications network, or as strictly necessary to provide an information society service expressly requested by you.
You may exercise your rights of access, rectification, erasure, objection, portability and restriction of the processing by sending a request to the Data Protection Officer via email (lopd@isglobal.org) or the ISGlobal postal address: c/ Rosselló, 132, 08036 Barcelona, Spain. The request must include your full name, address for notices, a photocopy of your ID document or passport and an indication of the right you want to exercise.
If you are unhappy with the processing done by ISGlobal or believe that your rights have been violated, you may file a claim with the Spanish Data Protection Agency at any time (www.aepd.es – C/ Jorge Juan, 6, Madrid).
ISGlobal has implemented the necessary technical and organizational security measures in order to guarantee the security of your personal data and prevent its alteration, loss, treatment and / or unauthorized access, considering the state of technology, the nature of the stored data and the risks to which they are exposed, whether they come from human action or the physical or natural environment, all in accordance with the provisions of current regulations.
In accordance with Law 34/2002, of 11 July, on the Services of the Information Society and Electronic Commerce, if you do not wish to receive electronic commercial notices from ISGlobal in the future, you may inform us of this preference by sending an email to the Data Protection Officer (lopd@isglobal.org).
[Updated on March 11, 2020 · Photo: Gilles Lambert / Unsplash]
When you visit any website, it may store or retrieve information on your browser, mostly in the form of cookies. This information might be about you, your preferences or your device and is mostly used to make the site work as you expect it to. The information does not usually directly identify you, but it can give you a more personalized web experience. Because we respect your right to privacy, you can choose not to allow some types of cookies. Click on the different category headings to find out more and change our default settings. However, blocking some types of cookies may impact your experience of the site and the services we are able to offer.
These cookies are necessary for the website to function and cannot be switched off in our systems. They are usually only set in response to actions made by you which amount to a request for services, such as setting your privacy preferences, logging in or filling in forms. You can set your browser to block or alert you about these cookies, but some parts of the site will not then work. These cookies do not store any personally identifiable information.
Cookies Details
| Cookie | Management | Duration | Aim |
|---|---|---|---|
| COOKIE_SUPPORT | First Party | 50 years | A cookie that checks whether cookies are enabled in your browser. |
| GUEST_LANGUAGE_ID | First Party | 50 years | Cookie used to remember the user's language preferences. |
| JSESSIONID | First Party | Session | Cookie used to manage web applications. |
| LFR_SESSION_STATE | First Party | Session | Liferay uses these cookies to manage your access ID |
| USER_UUID | First Party | Session | Liferay uses these cookies to manage your access ID |
| cp_sessionid | First Party | 5 years | |
| CK_CONSENT | First Party | 1 year | A cookie used to confirm the user's acceptance of first level cookies in response to the cookie warning. |
| COMPANY_ID | First Party | Session | Liferay company identifier |
| ID | First Party | Session | Liferay uses these cookies to manage your access ID |
| ck_fbanner | First Party | 14 days | A cookie used to check if the user already close footer banner. |
| ck_newsletter | First Party | 14 days | A cookie used to check if the user already close newsletter popup. |
| 1P_JAR | 1 month | These cookies are used to collect website statistics and track conversion rates. | |
| APISID | 2 years | Used by Google to store user preferences and information of Google | |
| HSID | 2 years | Used by Google to store user preferences and information of Google | |
| NID | 6 months | Advertising cookie used to tailor the advertisements shown to the interests of the user. | |
| S | Session | Used by Google to store user preferences and information of Google | |
| SAPISID | 2 years | Used by Google to store user preferences and information of Google | |
| SID | 2 years | Used by Google to store user preferences and information of Google | |
| SIDCC | 3 months | Used by Google to store user preferences and information of Google | |
| SSID | 2 years | Used by Google to store user preferences and information of Google | |
| __Secure-3PAPISID | 2 years | Used by for targeting purposes to build a profile of the website visitor's interests in order to show relevant & personalised Google advertising | |
| __Secure-3PSID | 2 years | Used by for targeting purposes to build a profile of the website visitor's interests in order to show relevant & personalised Google advertising | |
| __Secure-3PSIDCC | 2 years | Used by for targeting purposes to build a profile of the website visitor's interests in order to show relevant & personalised Google advertising | |
| CONSENT | 20 years | Used by Google to store user preferences and information of Google | |
| vuid | Vimeo | 2 years | A Vimeo Analytics cookie that provides a single id. |
| APISID | YouTube | 2 years | These cookies are set via embedded YouTube videos. They register anonymous statistical data |
| HSID | YouTube | 2 years | These cookies are set via embedded YouTube videos. They register anonymous statistical data |
| LOGIN_INFO | YouTube | 2 years | These cookies are set via embedded YouTube videos. They register anonymous statistical data |
| PREF | YouTube | 2 years | Cookie that remembers information that changes the appearance or behaviour of the web site, such as the user's preferred language or region. |
| SAPISID | YouTube | 2 years | These cookies are set via embedded YouTube videos. They register anonymous statistical data |
| SID | YouTube | 2 years | These cookies are set via embedded YouTube videos. They register anonymous statistical data |
| SIDCC | YouTube | 1 year | Used as security measure to protect users data from unauthorised access |
| SSID | YouTube | 2 years | These cookies are set via embedded YouTube videos. They register anonymous statistical data |
| VISITOR_INFO1_LIVE | YouTube | 1 year | A cookie that YouTube sets that measures your bandwidth to determine whether you get the new player interface or the old. |
| YSC | YouTube | Session | This cookie is set by the YouTube video service on pages with embedded YouTube video |
| CONSENT | YouTube | 20 years | Used by Google to store user preferences and information of Google |
| __Secure-3PAPISID | YouTube | 2 years | Used by for targeting purposes to build a profile of the website visitor's interests in order to show relevant & personalised Google advertising |
| __Secure-3PSID | YouTube | 2 years | Used by for targeting purposes to build a profile of the website visitor's interests in order to show relevant & personalised Google advertising |
| __Secure-3PSIDCC | YouTube | 2 years | Used by for targeting purposes to build a profile of the website visitor's interests in order to show relevant & personalised Google advertising |
| iutk | issuu | 10 years | Recognises the user's device and what Issuu documents have been read. |
| _initial_referrer | infogram | Session | Tells Infogram which site is embedding the content |
| ig_putma | infogram | Session | Session cookie |
These cookies allow us to count visits and traffic sources so we can measure and improve the performance of our site. They help us to know which pages are the most and least popular and see how visitors move around the site. All information these cookies collect is aggregated and therefore anonymous. If you do not allow these cookies we will not know when you have visited our site, and will not be able to monitor its performance.
Cookies Details
| Cookie | Management | Duration | Aim |
|---|---|---|---|
| _ga | Google Analytics | 2 years | This cookie is used to distinguishes unique users by assigning a randomly generated number as a client identifier. It is included in each page request in a site and used to calculate visitor, session and campaign data for the sites analytics reports. |
| _gat | Google Analytics | 1 minute | Used to throttle the request rate – limiting the collection of data on high traffic sites. |
| _gid | Google Analytics | 24 hours | Used to distinguish users |
Some of these cookies are set by a range of social media services that we have added to the site to enable you to share our content with your friends and networks. They are capable of tracking your browser across other sites and building up a profile of your interests. This may impact the content and messages you see on other websites you visit. If you do not allow these cookies you may not be able to use or see these sharing tools. Some other of these cookies may be set through our site by our advertising partners. They may be used by those companies to build a profile of your interests and show you relevant adverts on other sites. They do not store directly personal information but are based on uniquely identifying your browser and internet device. If you do not allow these cookies, you will experience less targeted advertising.
Cookies Details
| Cookie | Management | Duration | Aim |
|---|---|---|---|
| _gcl_au | 3 months | Used by Google for experimenting with advertisement efficiency | |
| IDE | Google (doubleclick) | 13 months | Used by Google to show relevant advertising to the viewer across the web |
| datr | 2 years | This cookie is used by facebook for security, to stop DDOS/fake accounts and to protect users content | |
| sb | 2 years | Allow you to control the “Follow us on Facebook” and “Like” buttons, collect the language settings and allow you to share the page. | |
| _fbp | 3 months | Store and track visits across websites. | |
| auth_token | 10 years | Track visitor activity from Twitter ads on our website, and also allow users to share content from our websites. They cookies do not provide us with any confidential information relating to your account. | |
| dnt | 10 years | These cookies enable users, if they wish, to login to their Twitter account share content from our websites with their friends. These cookies do not allow us access to your accounts or provide us with any confidential information relating to your accounts. | |
| twid | 10 years | Track visitor activity from Twitter ads on our website, and also allow users to share content from our websites. They cookies do not provide us with any confidential information relating to your account. | |
| wide | YouTube | Session | These cookies are set via embedded YouTube videos. They register anonymous statistical data |
| s_gl | YouTube | Session |